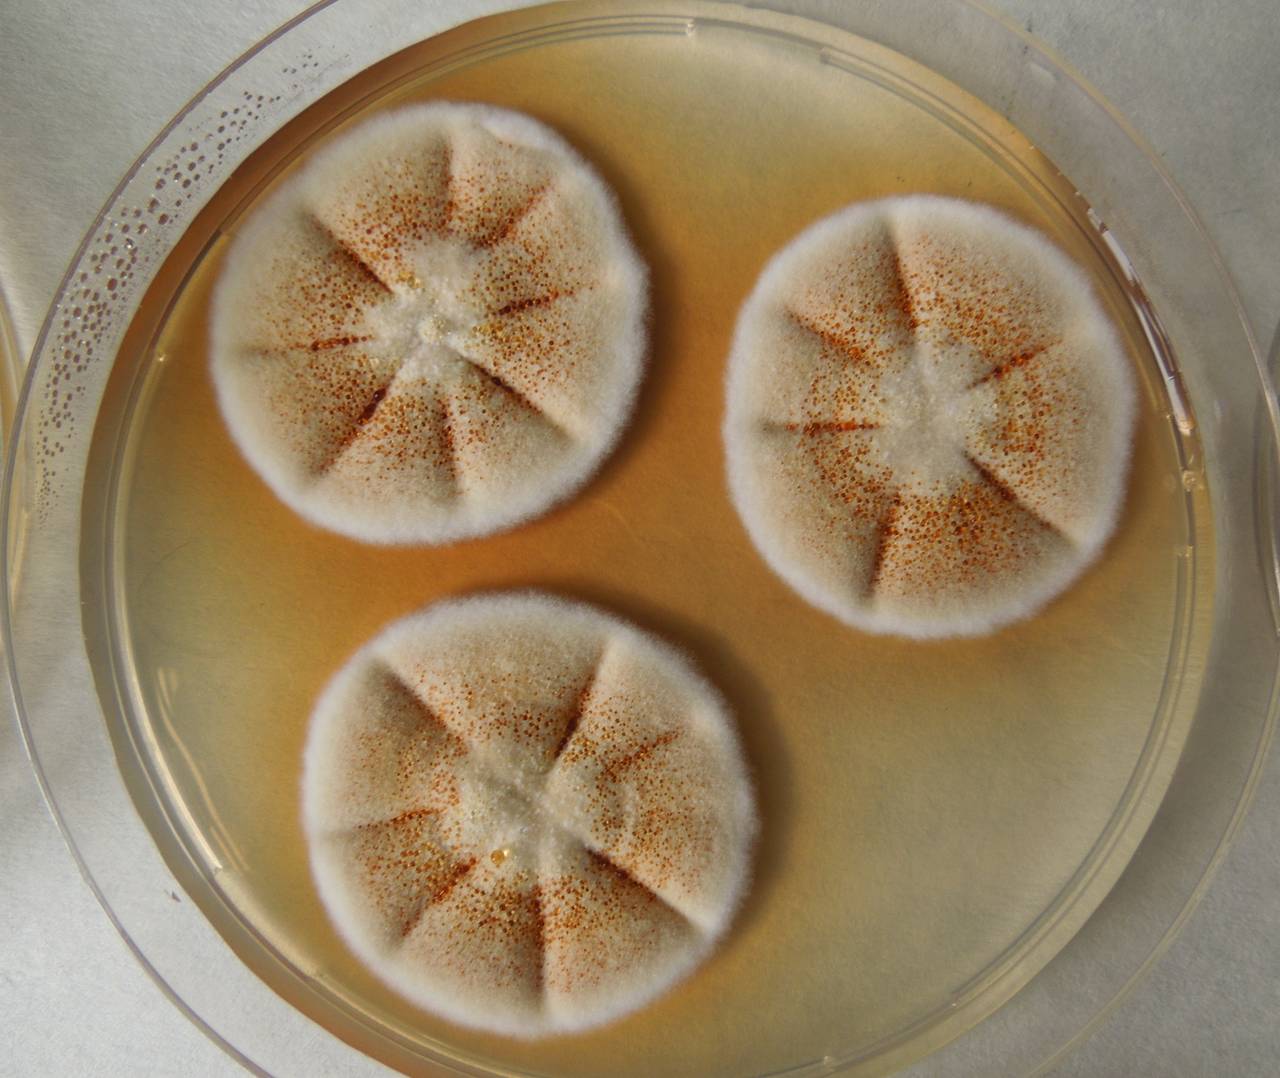

Пеницилл черный
Пеницилл черный 107 фотографий
Гриб груздь скрипун
Веточка сирени из бисера
Хроники мизантропа аудиокнига
Услуги разнорабочих ярославль
Скол без трещин на лобовом
Део нексия видео
Миксер планетарный бытовой
Zombie warfare 18
Автосуши автопицца нижегородская ул 3 фото
Пао т оренбургский филиал
Иксрос 3 мини зеленый
Минусы полимерной плитки
April сумки
Транспортная карта спутник
Indigo is 580
Тойота cargo
Wayward sisters
Свечи хендай акцент 1.5 артикул
Карта боев запорожье на сегодня
Статья 25 тк